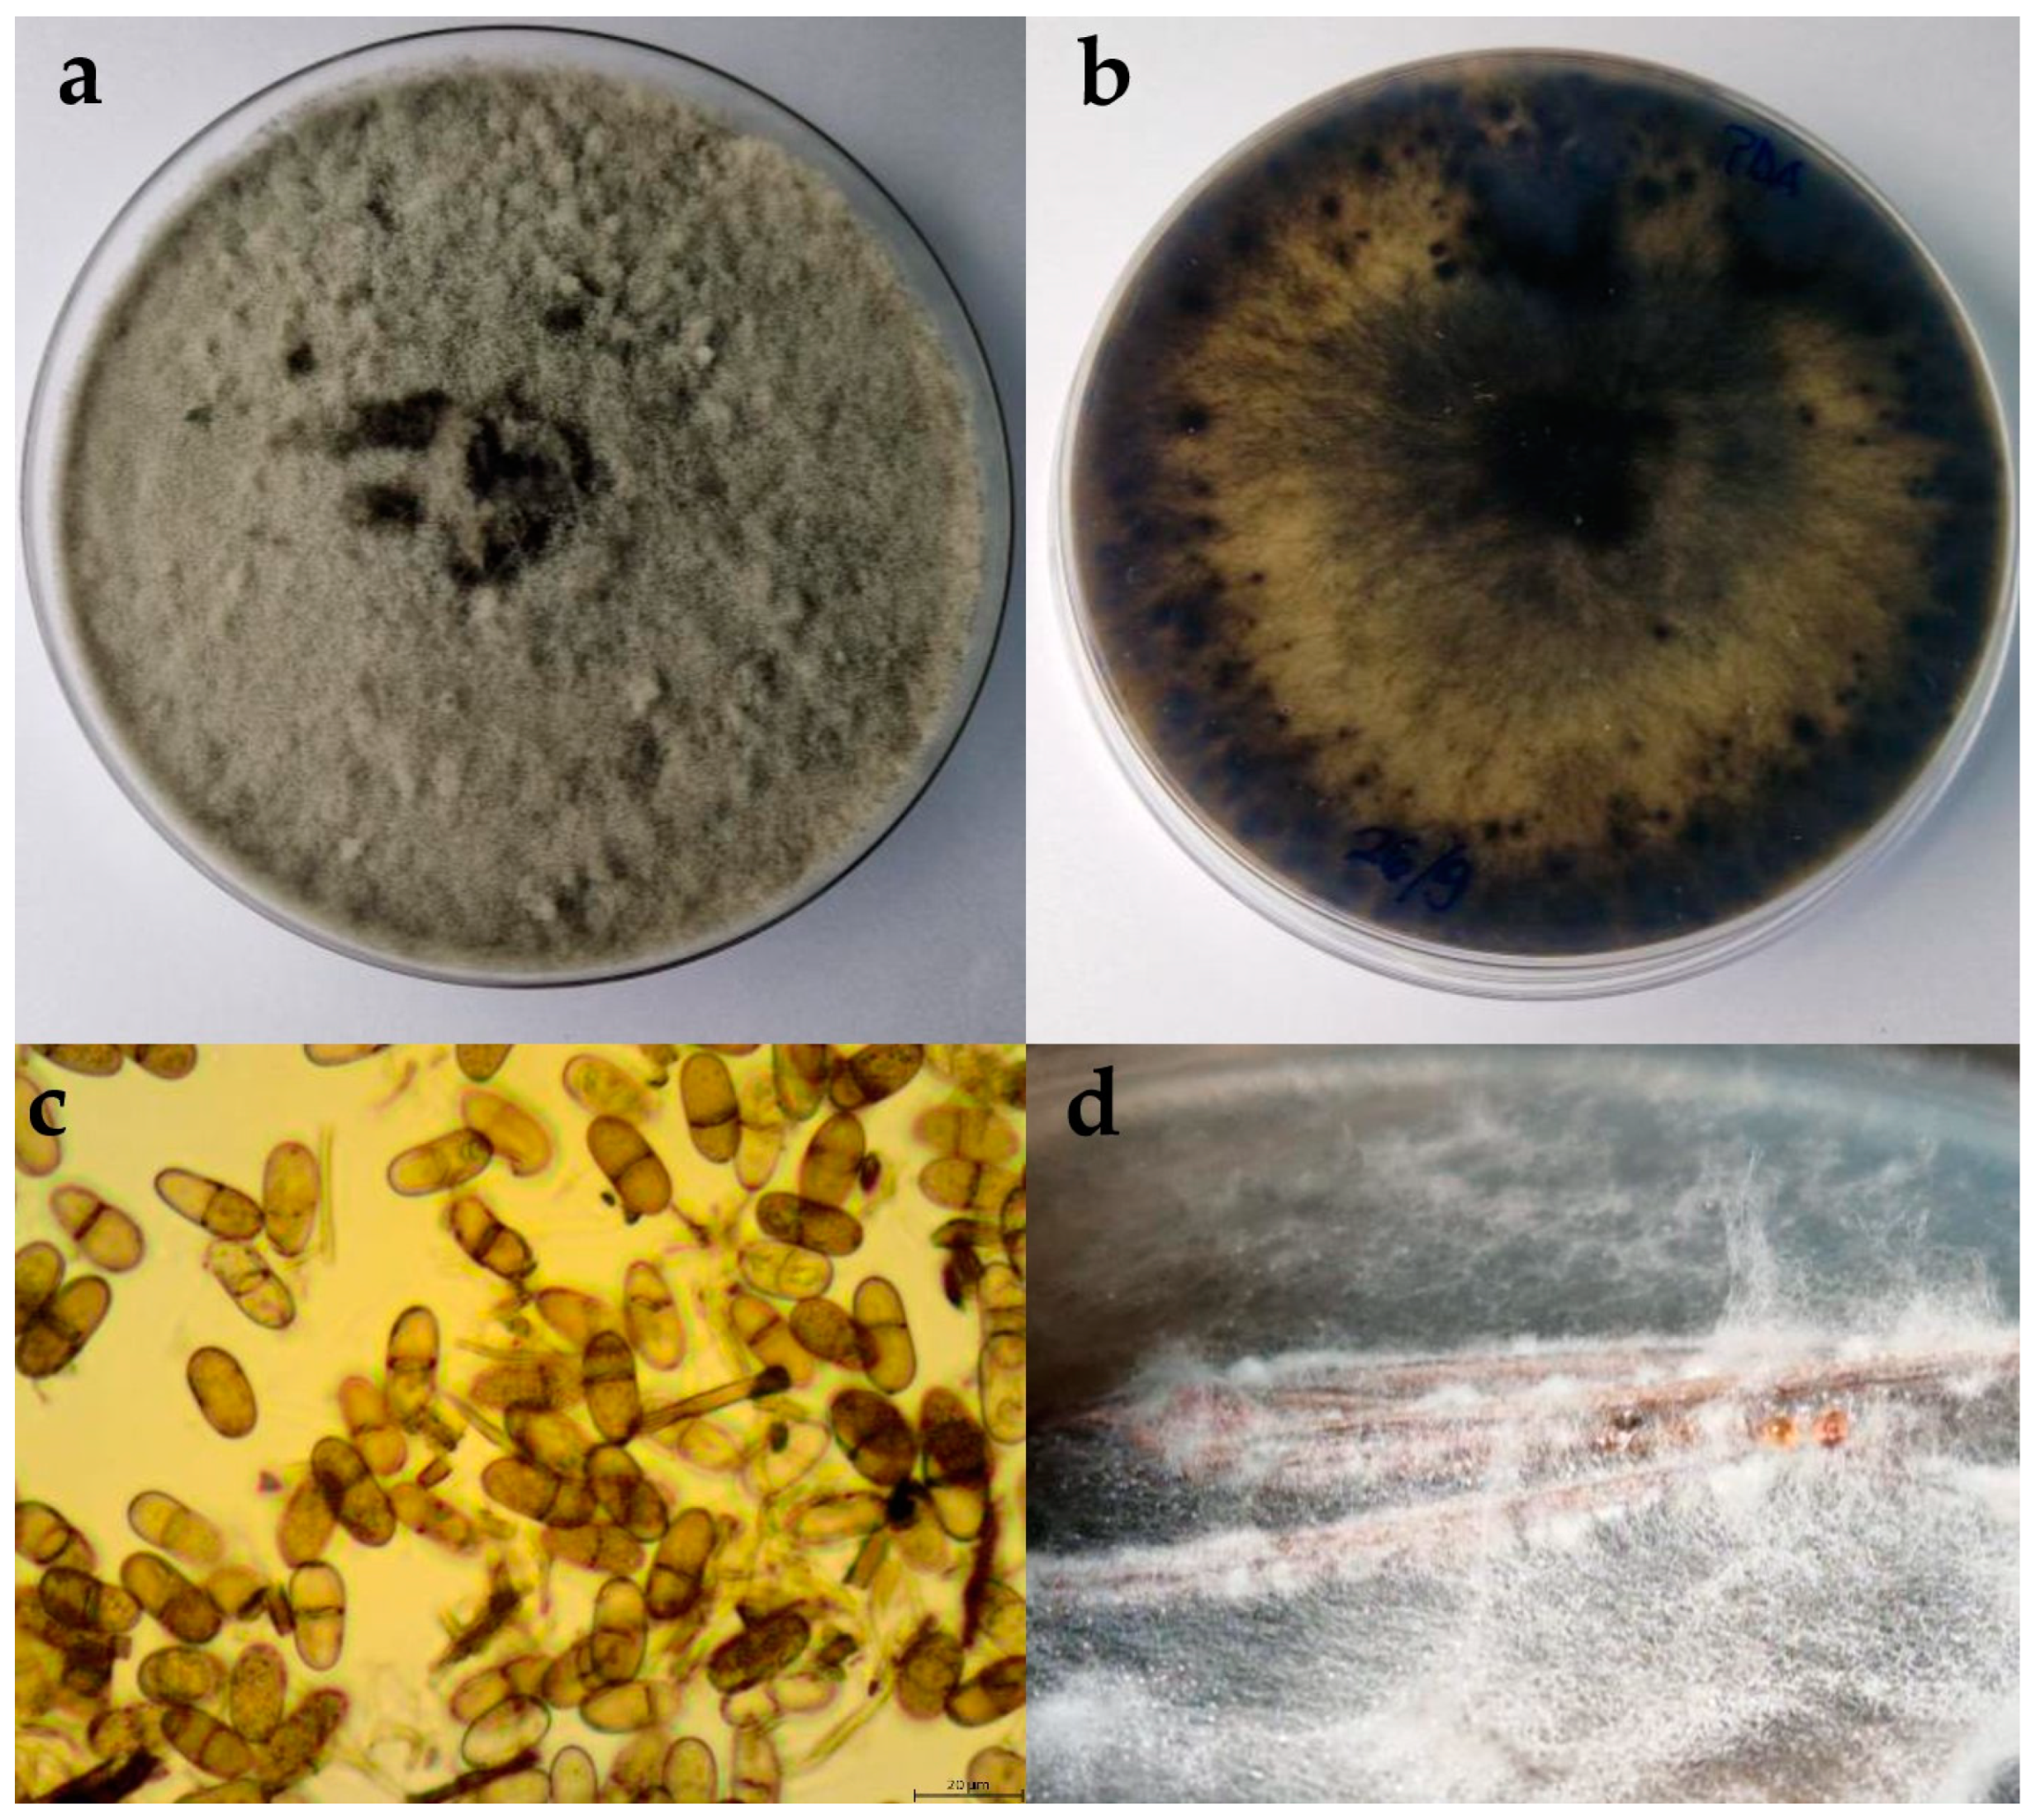
Plants 13 01813 g003
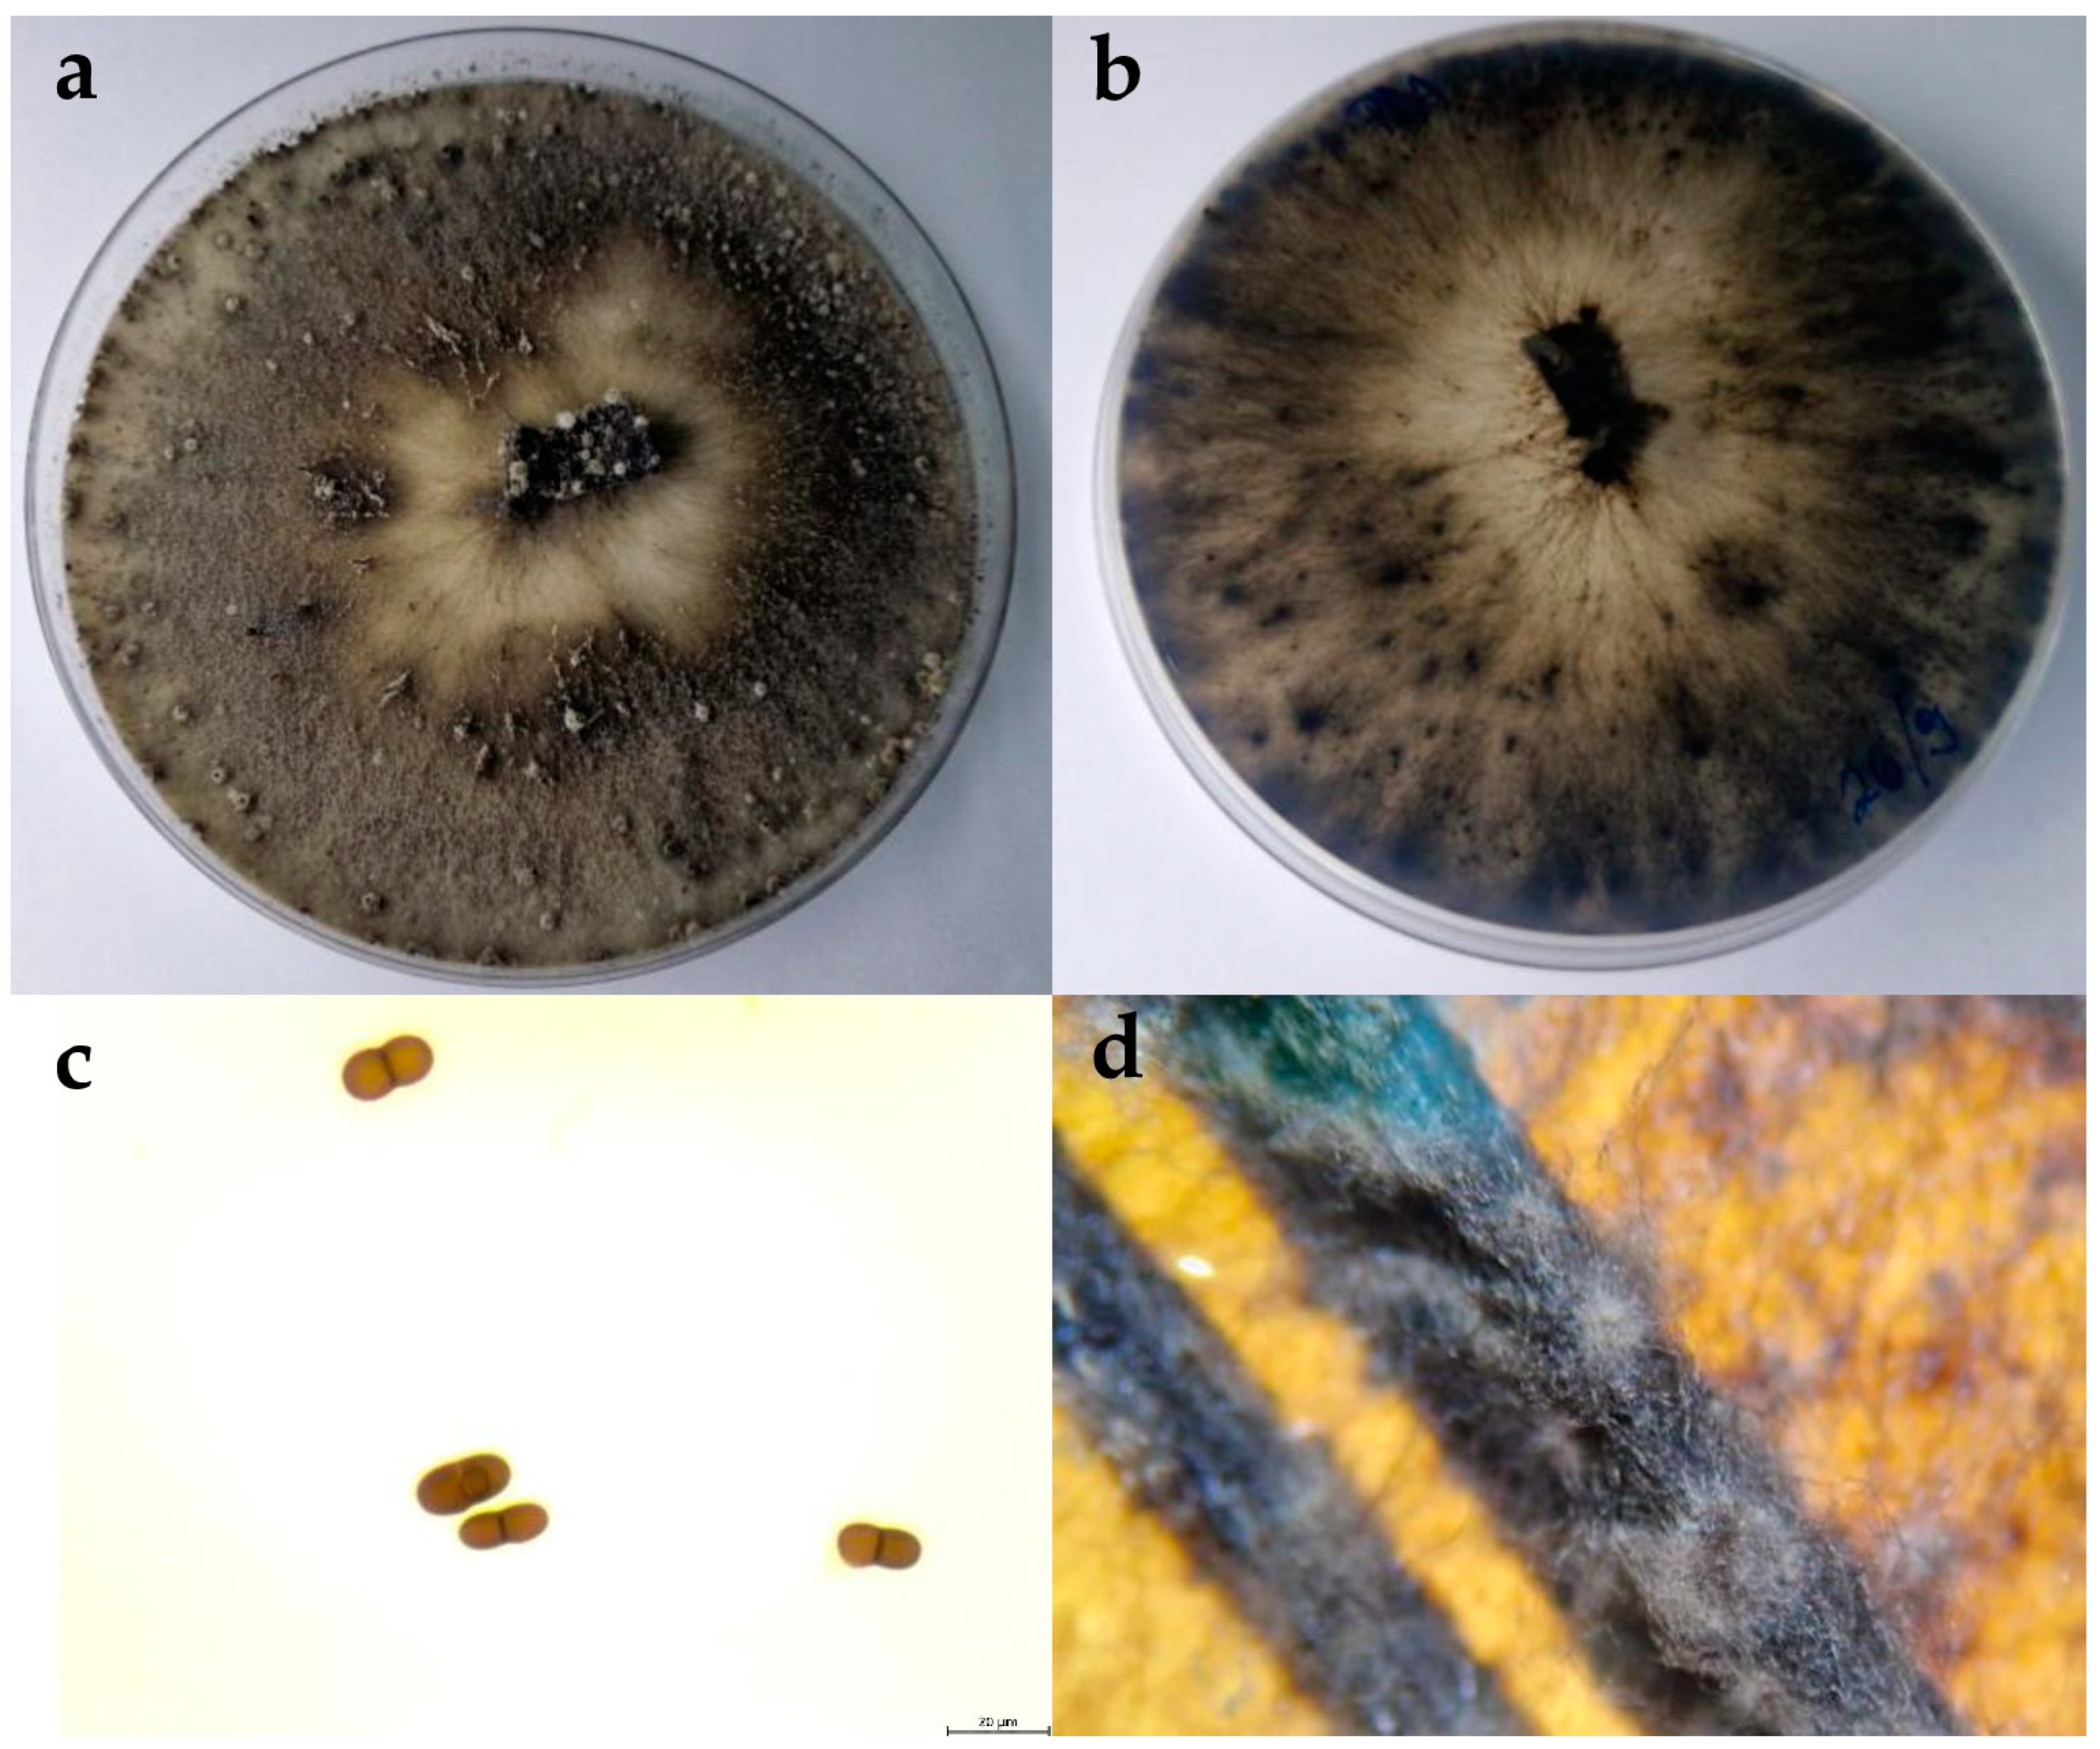
Plants 13 01813 g006
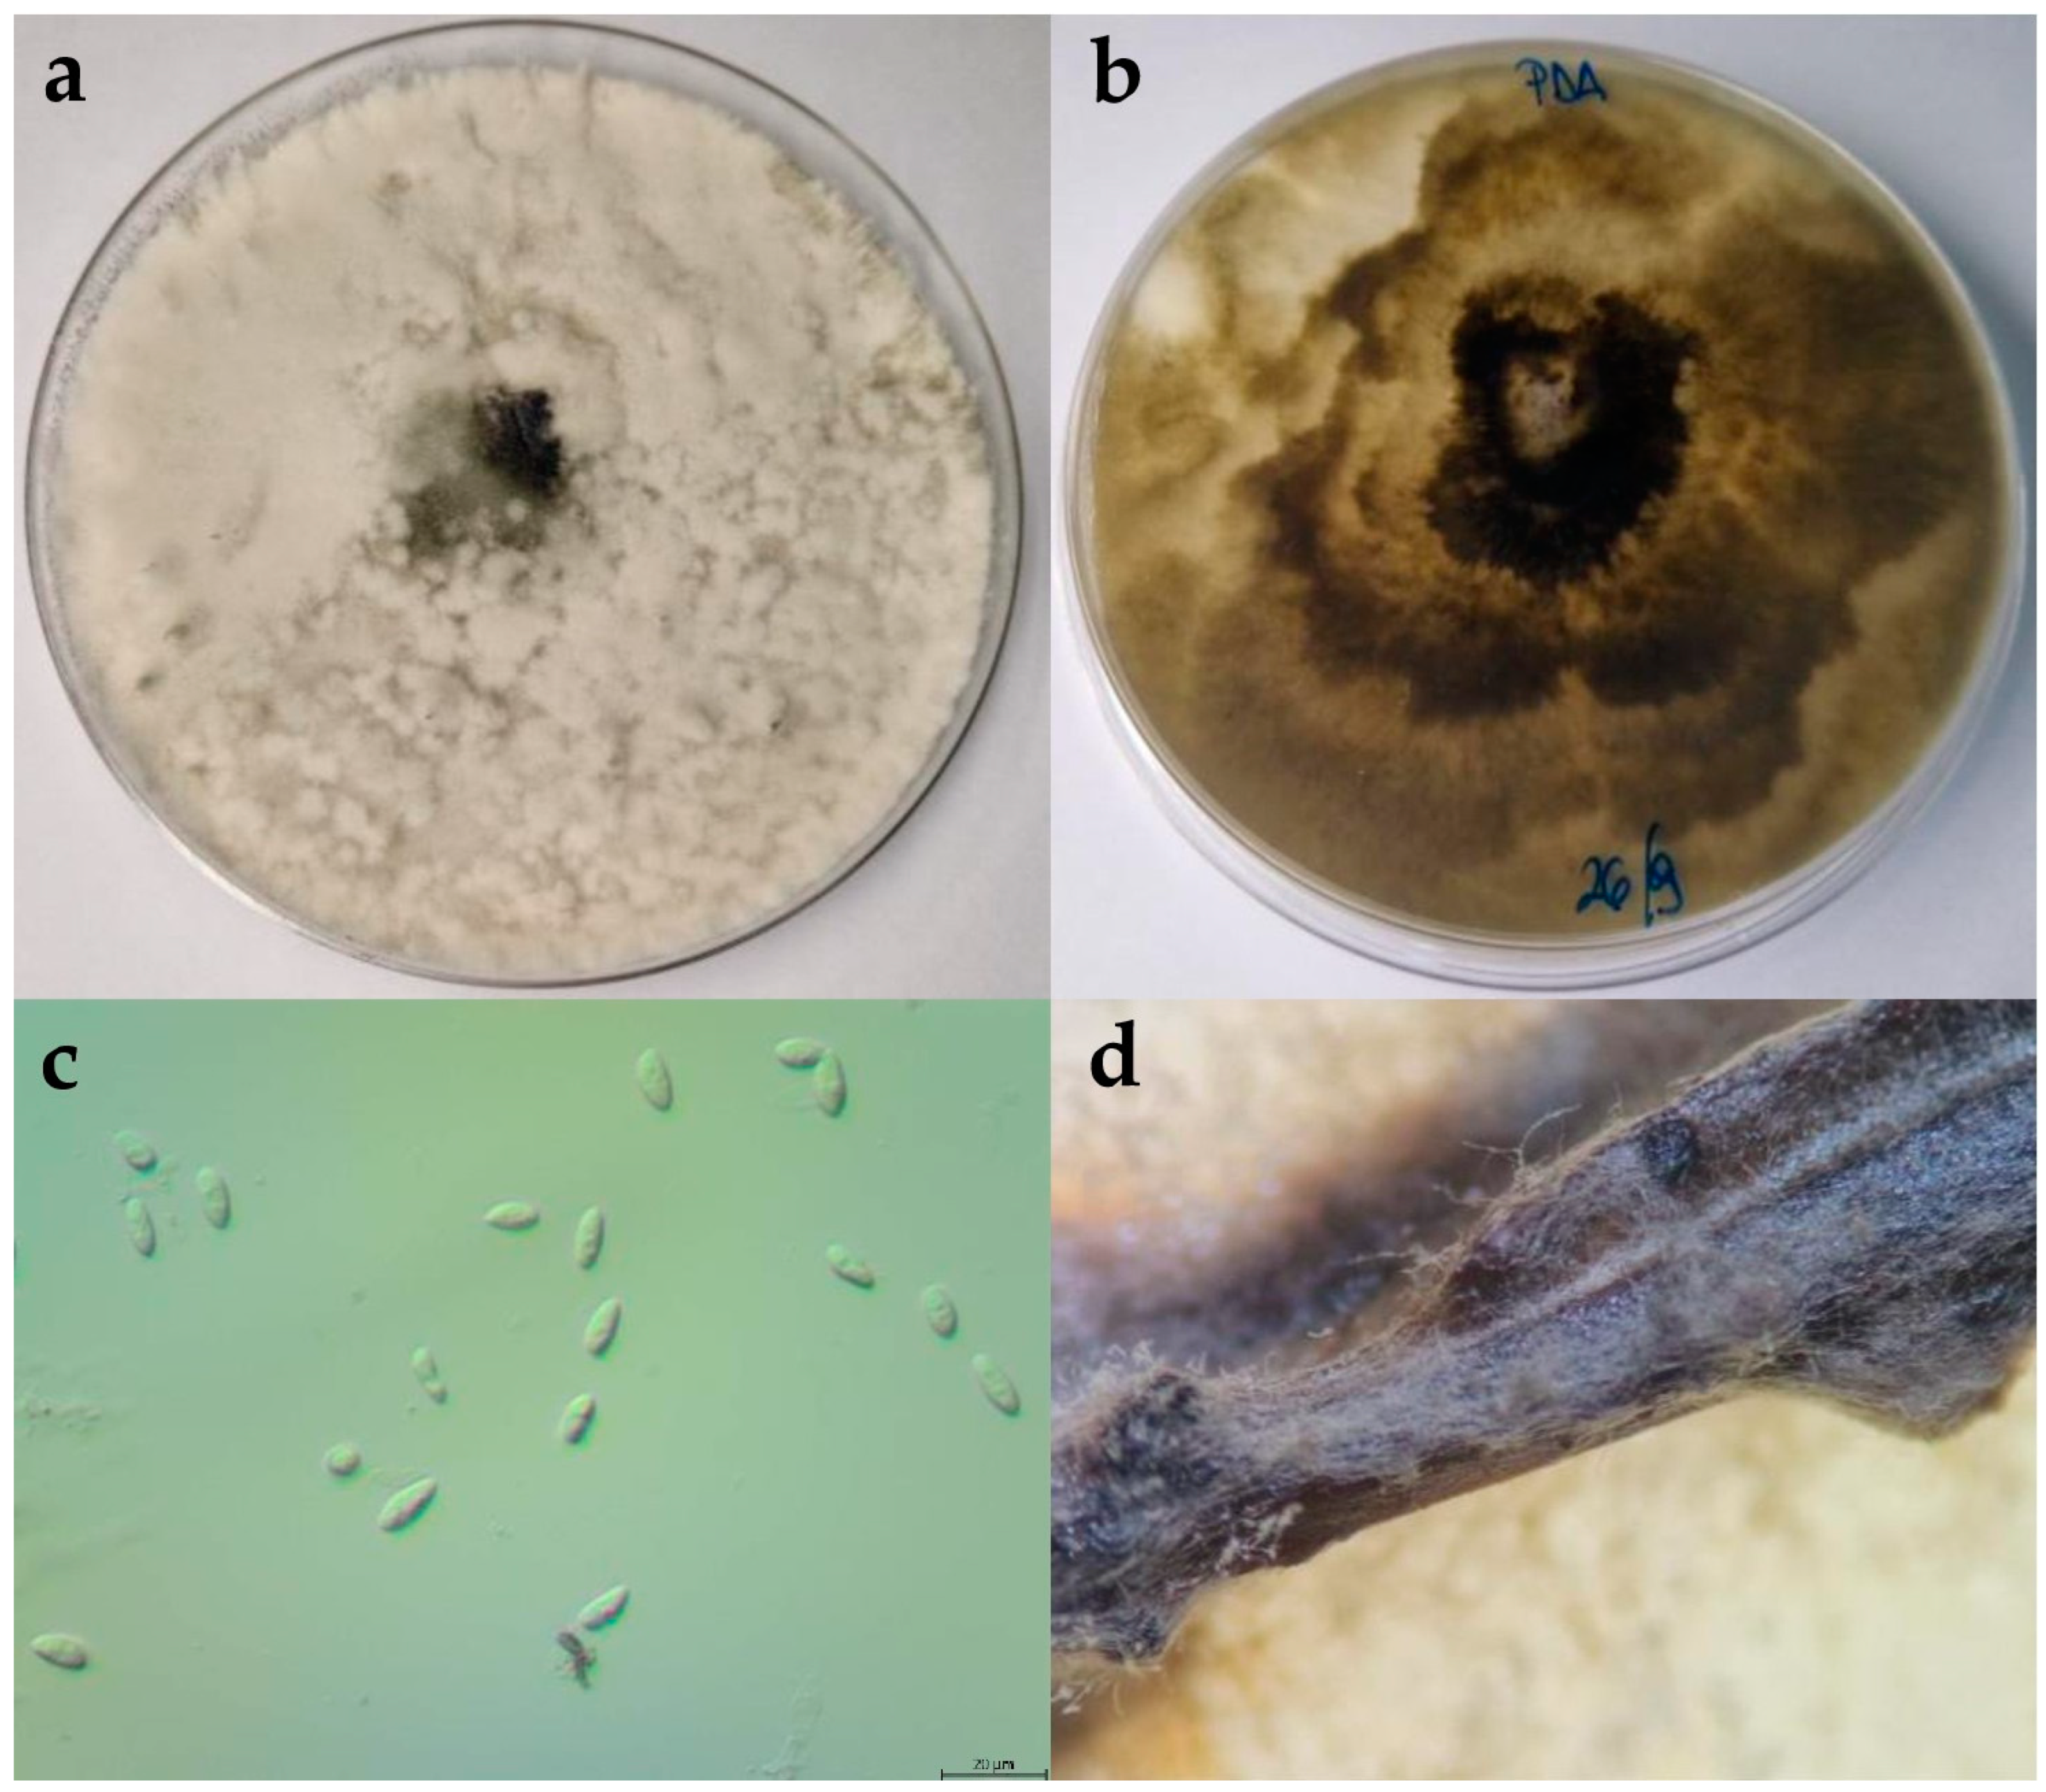
Plants 13 01813 g007

Diversity and Pathogenicity of Botryosphaeriaceae Species Isolated from Olives in Istria, Croatia, and Evaluation of Varietal Resistance
Abstract
1. Introduction
2. Results
2.1. Field Symptoms
2.2. Morphological Characterisation
2.2.1. Botryosphaeria Dothidea
2.2.2. Diplodia Mutila
2.2.3. Diplodia Seriata
2.2.4. Dothiorella Iberica
2.2.5. Dothiorella Sarmentorum
2.2.6. Neofusicoccum Parvum
2.2.7. Rate of Mycelial Growth
2.3. Molecular Phylogenetic Identification
2.4. Pathogenicity Test and Evaluation of Variety Resistance
2.4.1. Pathogenicity Test
2.4.2. Variety Resistance
3. Discussion
4. Materials and Methods
4.1. Fieldwork and Isolation of Fungi
4.2. Morphological Characterisation
4.3. DNA Extraction and Amplification
4.4. DNA Sequence Assembly and Phylogenetic Analysis
4.5. Pathogenicity Test and the Evaluation of Variety Resistance
5. Conclusions
Author Contributions
Funding
Data Availability Statement
Conflicts of Interest
References
- Pribetić, Đ. Sorte Maslina u Istri; MIH d.o.o.: Poreč, Croatia, 2006. [Google Scholar]
- Rosa, G. Storia dell’ Agricoltura Nella Civilitá; Forni: Bologna, Italy, 1883; p. 83. [Google Scholar]
- Hugues, C. Maslinarstvo Istre. Elaiografia Istriana; Ceres: Zagreb, Croatia, 1999. [Google Scholar]
- Del Fabro, A. Maslina—Uzgoj, Berba, korištenje; Leo Commerce d.o.o.: Rijeka, Croatia, 2015. [Google Scholar]
- Bertoša, M. Istarska Enciklopedija; Leksikografski Zavod Miroslav Krleža: Zagreb, Croatia, 2005. [Google Scholar]
- Godena, S.; Ivić, D.; Ban, D.; Gorena Ban, S. Characterization of Verticillium dahliae isolates from olive and susceptibility of local olive cultivars to Verticillium wilt in Istria, Croatia. Sci. Hortic. 2022, 292, 110630. [Google Scholar] [CrossRef]
- Bjeliš, M. Zaštita Masline u Ekološkoj Proizvodnji; Graf Form: Solin, Croatia, 2005. [Google Scholar]
- FAO—Food and Agriculture Organization of United Nations. Crop and Livestock Products. FAOSTAT. Available online: https://www.fao.org/faostat/en/#data (accessed on 29 May 2024).
- DZS—Državni Zavod za Statistiku. Proizvodnja Povrća, Voća i Grožđa u 2023—Privremeni Podaci. Available online: https://podaci.dzs.hr/2023/hr/58459 (accessed on 29 May 2024).
- Breton, C.; Terral, F.; Pinatel, C.; Médail, F.; Bonhomme, F.; Bervillé, A. The origins of the domestication of the olive tree. Comptes Rendus Biol. 2009, 332, 1059–1064. [Google Scholar] [CrossRef] [PubMed]
- Rugini, E.; Mencuccini, M.; Biasi, R.; Altamura, M.M. Olive (Olea europea L.). In Protocol for Somatic Embryogenesis in Woody Plants; Jain, S.M., Gupta, P.K., Eds.; Foresty Sciences; Springer: Dordrecht, The Netherlands, 2005; Volume 77, pp. 345–360. [Google Scholar]
- Schiestel, A. Olive Variety versus Cultivar. Available online: https://www.documentingolives.com/knowledge-centre/olive-variety-versus-cultivar/ (accessed on 29 May 2024).
- Monini. Olive Varieties. Available online: https://www.monini.com/en-gl/olive-varieties (accessed on 29 May 2024).
- HAPIH—Hrvatska Agencija za Poljoprivredu i Hranu. Popis Sorti Voćnih Vrsta. Available online: https://www.hapih.hr/csr/sortne-liste/ (accessed on 13 May 2024).
- Cvjetković, B. Mikoze i Pseudomikoze Voćnjaka i Vinoze Loze; Zrinski d.d.: Čakovec, Croatia, 2010. [Google Scholar]
- Kaliterna, J.; Miličević, T.; Ivić, D.; Benčić, D.; Mešić, A. First Report of Diplodia seriata as Causal Agent of Olive Dieback in Croatia. Plant Dis. 2012, 96, 290. [Google Scholar] [CrossRef]
- Godena, S.; Ivić, D.; Goreta Ban, S. Uzročnici Djelomičnog ili Potpunog Sušenja Stabala Maslina. Priručnik o Rezultatima VIP Projekta; Institute of Agriculture and Tourism: Poreč, Croatia, 2019. [Google Scholar]
- Ivić, D.; Petrović, E.; Godena, S. Fungi associated with canker diseases on olive in Istria (Croatia). J. Cent. Eur. Agric. 2023, 24, 470–475. [Google Scholar] [CrossRef]
- Petrović, E.; Godena, S.; Ćosić, J.; Vrandečić, K. Identification and Pathogenicity of Biscogniauxia and Sordaria Species Isolated from Olive Trees. Horticulturae 2024, 10, 243. [Google Scholar] [CrossRef]
- Ivić, D.; Ivanović, A.; Miličević, T.; Cvjetković, B. Shoot necrosis of olive caused by Phoma incompta, a new disease of olive in Croatia. Phytopathol. Mediterr. 2010, 49, 414–416. [Google Scholar]
- Petrović, E.; Vrandečić, K.; Ivić, D.; Ćosić, J.; Godena, S. First report of olive branch and fruit dieback in Croatia caused by Cytospora pruinosa Défago. Microorganisms 2023, 11, 1679. [Google Scholar] [CrossRef] [PubMed]
- Petrović, E.; Vrandečić, K.; Ćosić, J.; Godena, S. First report of Nigrospora species causing leaf spot on olive (Olea europaea L.). Horticulturae 2023, 9, 1067. [Google Scholar] [CrossRef]
- Petrović, E.; Vrandečić, K.; Ćosić, J.; Kanižai Šarić, G.; Godena, S. First report of Phaeoacremonium iranianum causing olive twig and branch dieback. Plants 2022, 11, 3578. [Google Scholar] [CrossRef]
- Ivić, D.; Tomić, Z.; Godena, S. First Report of Pleurostomophora richardsiae Causing Branch Dieback and Collar Rot of Olive in Istria, Croatia. Plant Dis. 2018, 102, 2648. [Google Scholar] [CrossRef]
- Buljubašić, I.; Bjeliš, M.; Marušić, I. Ocjena intenziteta napada paunovog oka [Spilocaea oleagina (Castagne) Hughes] na uzgojnim područjima masline. Glas. Biljn. Zaštite 2012, 12, 341–347. [Google Scholar]
- Cvjetković, B.; Vončina, D. Paunovo oko [Spilocaea oleaginea (Castagne) Hughes] najučestalija je bolest masline. Glas. Biljn. Zaštite 2012, 102, 336–340. [Google Scholar]
- Kaliterna, J.; Miličević, D.; Benčić, D.; Mešić, A. First Report of Verticillium Wilt Caused by Verticillium dahliae on Olive Trees in Croatia. Plant Dis. 2016, 100, 2526. [Google Scholar] [CrossRef]
- Vrsalović, M. Maslinarstvo i Uljarstvo za Puk; Vtalijani: Zadar, Croatia, 1901. [Google Scholar]
- Eldesouki-Arafat, I. Interacciones de Batrocera oleae Gmel. (Mosca del Olivo) con Botryosphaeria dothidea Moug. (Escudete de la Aceituna) y de Phloeotribus scarabaeoides Bern. (Barrenillo del Olivo) con Verticillium dahliae Kleb. Causante de la Verticilosis del Olivo. Ph.D. Thesis, University of Cordoba, Cordoba, Spain, 2013. [Google Scholar]
- Latinović, J.; Mazzaglia, A.; Latinović, N.; Ivanović, M.; Gleason, M.L. Resistance of olive cultivars to Botryosphaeria dothidea, causal agent of olive fruit rot in Montenegro. Crop Prot. 2013, 48, 35–40. [Google Scholar] [CrossRef]
- Moral, J.; Muñoz-Diez, C.; Gonzalez, N.; Trapero, A.; Michailides, T.J. Characterization and Pathogenicity of Botryosphaeriaceae Species Collected from Olive and Other Hosts in Spain and California. Phytopathology 2010, 100, 1340–1351. [Google Scholar] [CrossRef]
- Hernández-Rodríguez, L.; Mondino-Hintz, P.; Alaniz-Ferro, S. Diversity of Botryosphaeriaceae species causing stem canker and fruit rot in olive trees in Uruguay. J. Phytopathol. 2022, 170, 264–277. [Google Scholar] [CrossRef]
- Lazzizera, C.; Frisullo, S.; Alves, A.; Phillips, A.J.L. Morphology, phylogeny and pathogenicity of Botryosphaeria and Neofusicoccum species associated with drupe rot of olives in southern Italy. Plant Pathol. 2008, 57, 948–956. [Google Scholar] [CrossRef]
- Lazzizera, C.; Frisullo, S.; Alves, A.; Lopes, J.; Phillips, A.J.L. Phylogeny and morphology of Diplodia species on olives in southern Italy and description of Diplodia olivarum sp. nov. Fungal Divers. 2008, 31, 63–71. [Google Scholar]
- Carlucci, A.; Raimondo, M.L.; Cibelli, F.; Phillips, A.J.L.; Lops, F. Pleurostomophora richardsiae, Neofusicoccum parvum and Phaeoacremonium aleophilum associated with a decline of olives in southern Italy. Phytopathol. Mediterr. 2013, 52, 517–527. [Google Scholar]
- Úrbez-Torres, J.R.; Peduto, F.; Vossen, P.M.; Krueger, W.H.; Gubler, W.D. Olive Twig and Branch Dieback: Etiology, Incidence, and Distribution in California. Plant Dis. 2013, 97, 231–244. [Google Scholar] [CrossRef]
- Phillips, A.J.L.; Alves, A.; Abdollahzadeh, J.; Slippers, B.; Wingfield, M.J.; Groenewald, J.Z.; Crous, P.W. The Botryosphaeriaceae: Genera and species known from culture. Stud. Mycol. 2013, 76, 51–167. [Google Scholar] [CrossRef] [PubMed]
- Amponsah, N.T.; Jones, E.E.; Ridgway, H.J.; Jaspers, M.V. Rainwater dispersal of Botryosphaeria conidia from infected grapevines. N. Z. Plant Prot. 2009, 62, 228–233. [Google Scholar] [CrossRef]
- Lehoczky, J. Black dead-arm disease of grapevine caused by Botryosphaeria stevensii infection. Acta Phytopathol. Acad. Sci. Hung. 1974, 9, 319–327. [Google Scholar]
- Van Nieker, J.M.; Fourie, P.H.; Hallen, F.; Crous, P.W. Botryosphaeria spp. as grapevine trunk disease pathogens. Phytopathol. Mediterr. 2006, 45, S43–S54. [Google Scholar]
- Schoch, C.L.; Ciufo, S.; Domrachev, M.; Hotton, C.L.; Kannan, S.; Khovanskaya, R.; Leipe, D.; Mcveigh, R.; O’Neill, K.; Robbertse, B.; et al. NCBI Taxonomy: A comprehensive update on curation, resources and tools. Database 2020, 2020, baaa062. [Google Scholar] [CrossRef] [PubMed]
- Mycobank. Botryosphaeriaceae. Available online: https://www.mycobank.org/page/Name%20details%20page/name/Botryosphaeriaceae (accessed on 3 June 2024).
- Kaliterna, J. Identifikacija, Patogenost i Rasprostranjenost Vrsta Gljiva iz Porodice Botryosphaeriaceae i Diaporthaceae na Vinovoj Lozi u Hrvatskoj. Ph.D. Thesis, University in Zagreb, Faculty of Agriculture, Zagreb, Croatia, 2013. [Google Scholar]
- EPPO. European and Mediterranean Plant Protection Organization. Bull. OEPP/EPPO Bull. 2016, 46, 501–537. [Google Scholar]
- Romero, M.A.; Sánchez, M.E.; Trapero, A. First report of Botryosphaeria ribis as a branch dieback pathogen of olive trees in Spain. Plant Dis. 2005, 89, 208. [Google Scholar] [CrossRef] [PubMed]
- Moral, J.; Agustí-Brisach, C.; Pérez-Rodríguez, M.; Xavíer, C.; Raya, M.C.; Rhouma, A.; Trapero, A. Identification of Fungal Species Associated with Branch Dieback of Olive and Resistance of Table Cultivars to Neofusicoccum mediterraneum and Botryosphaeria dothidea. Plant Dis. 2017, 107, 306–316. [Google Scholar] [CrossRef] [PubMed]
- Spies, C.F.J.; Mostert, L.; Carlucci, A.; Moyo, P.; van Jaarsveld, W.J.; du Plessis, I.L.; van Dyk, M.; Halleen, F. Dieback and decline pathogens of olive trees in South Africa. Persoonia 2020, 45, 196–220. [Google Scholar] [CrossRef]
- Linaldeddu, B.T.; Rossetto, G.; Maddau, L.; Vatrano, T.; Bregant, C. Diversity and Pathogenicity of Botryosphaeriaceae and Phytophthora Species Associated with Emerging Olive Diseases in Italy. Agriculture 2023, 13, 1575. [Google Scholar] [CrossRef]
- Yan, J.-Y.; Xie, Y.; Zhang, W.; Wang, Y.; Liu, J.K.; Hyde, K.D.; Seem, R.C.; Zhang, G.-Z.; Wang, Z.-Y.; Yao, S.-W.; et al. Species of Botryosphaeriaceae involved in grapevine dieback in China. Fungal Divers. 2013, 61, 221–236. [Google Scholar] [CrossRef]
- Langer, G.J.; Bußkamp, J. Fungi Associated with Woody Tissues of European Beech and Their Impact on Tree Health. Front. Microbiol. 2021, 12, 702467. [Google Scholar] [CrossRef] [PubMed]
- Endes, A.; Kayim, M. Morphological and Molecular Characterization of Botryosphaeriaceae Species Associated with Dieback And Gummosis On Plum Trees In Turkey. Comptes Rendus L Acad. Bulg. Sci. 2022, 75, 295–302. [Google Scholar] [CrossRef]
- Novak, A.; Ivić, D.; Sever, Z.; Fazinić, T.; Šimunac, K. Gljivični rak oraha u Hrvatskoj. Glas. Biljn. Zaštite 2018, 3, 316–321. [Google Scholar]
- Kovač, M.; Diminić, D.; Orlović, S.; Zlatković, M. Botryosphaeria Dothidea and Neofusicoccum Yunnanense Causing Canker and Die-Back of Sequoiadendron Giganteum in Croatia. Forests 2021, 12, 695. [Google Scholar] [CrossRef]
- Marcianó, D.; Mizzotti, C.; Maddalena, G.; Toffolatti, S. The dark side of fungi: How they cause diseases in plants. Front. Young Minds 2021, 9, 560315. [Google Scholar] [CrossRef]
- Gramaje, D.; Úrbez-Torres, J.R.; Sosnowski, M.R. Managing Grapevine Trunk Diseases with Respect to Etiology and Epidemiology: Current Strategies and Future Prospects. Plant Dis. 2018, 102, 12–39. [Google Scholar] [CrossRef] [PubMed]
- Pitt, W.M.; Sosnowski, M.R.; Huang, R.; Qiu, Y.; Steel, C.C.; Savocchia, S. Evaluation of Fungicides for the Management of Botryosphaeria Canker of Grapevines. Plant Dis. 2012, 96, 1303–1308. [Google Scholar] [CrossRef] [PubMed]
- Díaz, G.; Latorre, B. Efficacy of paste and liquid fungicide formulations to protect pruning wounds against pathogens associated with grapevine trunk diseases in Chile. Crop Prot. 2013, 46, 106–112. [Google Scholar] [CrossRef]
- Amponsah, N.T.; Jones, E.; Ridgway, H.J.; Jaspers, M.V. Evaluation of fungicides for the management of Botryosphaeria dieback diseases of grapevines. Pest Manag. Sci. 2012, 68, 676–683. [Google Scholar] [CrossRef]
- Sánchez, M.E.; Venegas, J.; Romero, M.A.; Phillips, A.J.L.; Trapero, A. Botryosphaeria and related taxa causing oak canker in southwestern Spain. Plant Dis. 2003, 87, 1515–1521. [Google Scholar] [CrossRef]
- White, T.J.; Bruns, T.D.; Lee, S.B.; Taylor, J.W. 38—Amplification and direct sequencing of fungal ribosomal RNA genes forphylogenetics. In PCR—Protocols and Applications—A Laboratory Manual; Innis, M.A., Gelfand, D.H., Sninsky, J.J., White, T.J., Eds.; Academic Press Inc.: Cambridge, MA, USA, 1990; pp. 315–322. [Google Scholar]
- Glass, N.L.; Donaldson, G.C. Development of primer sets designed for use with the PCR to amplify conserved genes from filamentous ascomycetes. Appl. Environ. Microbiol. 1995, 61, 1323–1330. [Google Scholar] [CrossRef]
- Carbone, I.; Kohn, L.M. A Method for Designing Primer Sets for Speciation Studies in Filamentous Ascomycetes. Mycologia 1995, 91, 553–556. [Google Scholar] [CrossRef]
- Slippers, B.; Crous, P.W.; Denman, S.; Coutinho, T.A.; Wingfield, B.D.; Wingfield, M.J. Combined multiple gene genealogies and phenotypic characters differentiate several species previously identified as Botryosphaeria dothidea. Mycologia 2004, 96, 83–101. [Google Scholar] [CrossRef] [PubMed]
- Saitou, N.; Nei, M. The neighbor-joining method: A new method for reconstructing phylogenetic trees. Mol. Biol. Evol. 1987, 4, 406–425. [Google Scholar] [PubMed]
- Felsenstein, J. Confidence limits on phylogenies: An approach using the bootstrap. Evolution 1985, 39, 783–791. [Google Scholar] [CrossRef]
- Tamura, K.; Nei, M.; Kumar, S. Prospects for inferring very large phylogenies by using the neighbor-joining method. Proc. Natl. Acad. Sci. USA 2004, 101, 11030–11035. [Google Scholar] [CrossRef]
- Tamura, K.; Stecher, G.; Kumar, S. MEGA 11: Molecular Evolutionary Genetics Analysis Version 11. Mol. Biol. Evol. 2021, 38, 3022–3027. [Google Scholar] [CrossRef] [PubMed]
- Henriques, J.; Nóbrega, F.; Sousa, E.; Lima, A. Analysis of the genetic diversity and phylogenetic relationships of Biscogniauxia mediterranea isolates associated with cork oak. Phytoparasitica 2016, 44, 19–34. [Google Scholar] [CrossRef]
- Phillips, A.J.L.; Oudemans, P.V.; Correia, A.; Alves, A. Characterisation and epitypification of Botryosphaeria corticis, the cause of blueberry cane canker. Fungal Divers. 2006, 2, 141–155. [Google Scholar]
- Alves, A.; Correia, A.; Luque, J.; Phillips, A. Botryosphaeria corticola, sp. nov. on Quercus species, with notes and description of Botryosphaeria stevensii and its anamorph, Diplodia mutila. Mycologia 2004, 96, 598–613. [Google Scholar] [PubMed]
- Phillips, A.; Alves, A.; Correia, A.; Luque, J. Two new species of Botryosphaeria with brown, 1-septate ascospores and Dothiorella anamorphs. Mycologia 2005, 97, 513–529. [Google Scholar] [CrossRef] [PubMed]
- Phillips, A.J.L.; Alves, A.; Pennycook, S.R.; Johnston, P.R.; Ramaley, A.; Akulov, A.; Crous, P.W. Resolving the phylogenetic and taxonomic status of dark-spored teleomorph genera in the Botryosphaeriaceae. Persoonia 2008, 21, 29–55. [Google Scholar] [CrossRef] [PubMed]
- Li, G.Q.; Liu, F.F.; Li, J.Q.; Liu, Q.L.; Chen, S.F. Botryosphaeriaceae from Eucalyptus plantations and adjacent plants in China. Persoonia 2018, 40, 63–95. [Google Scholar] [CrossRef] [PubMed]
- Zhuang, C.J.; Wang, Q.W.; Wu, Q.Q.; Qiu, Z.L.; Xu, B.C.; Zhang, C.Q. Diversity of Botryosphaeriaceae Species Associated with Chinese Hickory Tree (Carya cathayensis) Trunk Cankers. Plant Dis. 2021, 105, 3869–3879. [Google Scholar] [CrossRef] [PubMed]
- Elfar, K.; Carachure, C.; Bustamante, M.I.; Andrews, E.; Eskalen, A. First report of Diplodia bulgarica causing black canker on apple in California. Plant Dis. 2024, 108, 531. [Google Scholar] [CrossRef]
- Phillips, A.J.L.; Lopes, J.; Abollahzadeh, J.; Bobev, S.; Alves, A. Resolving the Diplodia complex on apple and other Rosaceae hosts. Persoonia 2012, 29, 29–38. [Google Scholar] [CrossRef]
- Vu, D.; Groenewald, M.; de Vries, M.; Gehrmann, T.; Stielow, B.; Eberhardt, U.; Al-Hatmi, A.; Groenewald, J.Z.; Cardinali, G.; Houbraken, J.; et al. Large-scale generation and analysis of filamentous fungal DNA barcodes boosts coverage for kingdom fungi and reveals thresholds for fungal species and higher taxon delimitation. Stud. Mycol. 2019, 92, 135–154. [Google Scholar] [CrossRef]
- Zhang, W.; Groenewald, J.Z.; Lombard, L.; Schumacher, R.K.; Phillips, A.J.L.; Crous, P.W. Evaluating species in Botryosphaeriales. Persoonia 2021, 46, 63–115. [Google Scholar] [CrossRef]
- Úrbez-Torres, J.R.; Peduto, F.; Rooney-Latham, S.; Gubler, W.D. First Report of Diplodia corticola Causing Grapevine (Vitis vinifera) Cankers and Trunk Cankers and Dieback of Canyon Live Oak (Quercus chrysolepis) in California. Plant Dis. 2010, 94, 785. [Google Scholar] [CrossRef]
- Alves, A.; Correia, A.; Phillips, A.J.L. Multi-gene genealogies and morphological data support Diplodia cupressi sp. nov., previously recognized as D. pinea f. sp. cupressi, as a distinct species. Fungal Divers. 2006, 23, 1–15. [Google Scholar]
- Zhao, P.; Crous, P.W.; Hou, L.W.; Duan, W.J.; Cai, L.; Ma, Z.Y.; Liu, F. Fungi of quarantine concern for China I: Dothideomycetes. Persoonia 2021, 47, 45–105. [Google Scholar] [CrossRef] [PubMed]
- Inderbitzin, P.; Bostock, R.M.; Trouillas, F.P.; Michailides, T.J. A six locus phylogeny reveals high species diversity in Botryosphaeriaceae from California almond. Mycologia 2010, 102, 1350–1368. [Google Scholar] [CrossRef] [PubMed]
- Jami, F.; Slippers, B.; Wingfield, M.; Gryzenhout, M. Five new species of Botryosphaeriaceae from Acacia Karroo in South Africa. Cryptogam. Mycol. 2012, 33, 245–266. [Google Scholar] [CrossRef]
- Schoch, C.L.; Robbertse, B.; Robert, V.; Vu, D.; Cardinali, G.; Irinyi, L.; Meyer, W.; Nilsson, R.H.; Hughes, K.; Miller, A.N.; et al. Finding needles in haystacks: Linking scientific names, reference specimens and molecular data for Fungi. Database (Oxford) 2014, 2014, bau061. [Google Scholar] [CrossRef] [PubMed]
- Doll, D.A.; Rolshausen, P.E.; Pouzoulet, J.; Michailides, T.J. First Report of Dothiorella iberica Causing Trunk and Scaffold Cankers of Almond in California. Plant Dis. 2015, 99, 1185. [Google Scholar] [CrossRef]
- der Walt, F.J.J. Botryosphaeriaceae Associated with Acacia Species in Southern Africa with Special Reference to A. mellifera. Magister Scientae, University of Pretoria, Faculty of Natural and Agricultural Sciences, Pretoria, South Africa, 2008. [Google Scholar]
- Yang, T.; Groenewald, J.Z.; Cheewangkoon, R.; Jami, F.; Abdollahzadeh, J.; Lombard, L.; Crous, P.W. Families, genera, and species of Botryosphaeriales. Fungal Biol. 2017, 121, 322–346. [Google Scholar] [CrossRef] [PubMed]
- Slippers, B.; Boissin, E.; Phillips, A.J.L.; Groenewald, J.Z.; Lombard, L.; Wingfield, M.J.; Postma, A.; Burgess, T.; Crous, P.W. Phylogenetic lineages in the Botryosphaeriales: A systematic and evolutionary framework. Stud. Mycol. 2013, 76, 31–49. [Google Scholar] [CrossRef] [PubMed]
- Zlatković, M.; Keča, N.; Wingfield, M.J.; Jami, F.; Slippers, B. Botryosphaeriaceae associated with the die-back of ornamental trees in the Western Balkans. Antonie Leeuwenhoek 2016, 109, 543–564. [Google Scholar]
- Úrbez-Torres, J.R.; Peduto, F.; Gubler, W. First Report of Grapevine Cankers Caused by Lasiodiplodia crassispora and Neofusicoccum mediterraneum in California. Plant Dis. 2010, 94, 785. [Google Scholar] [CrossRef]
- Burgess, T.I.; Barber, P.A.; Mohali, S.; Pegg, G.; de Beer, W.; Wingfield, M.J. Three new Lasiodiplodia spp. from the tropics, recognized based on DNA sequence comparisons and morphology. Mycologia 2006, 98, 423–435. [Google Scholar] [CrossRef] [PubMed]
- Cruywagen, E.M.; Slippers, B.; Roux, J.; Wingfield, M.J. Phylogenetic species recognition and hybridisation in Lasiodiplodia: A case study on species from baobabs. Fungal Biol. 2017, 121, 420–436. [Google Scholar] [CrossRef] [PubMed]
- Osorio, J.A.; Crous, C.J.; de Beer, Z.W.; Wingfield, M.J.; Roux, J. Endophytic Botryosphaeriaceae, including five new species, associated with mangrove trees in South Africa. Fungal Biol. 2017, 121, 361–393. [Google Scholar] [CrossRef] [PubMed]
- Ko, Y.Z.; Liyanage, W.K.; Shih, H.C.; Tseng, M.N.; Shiao, M.S.; Chiang, Y.C. Unveiling Cryptic Species Diversity and Genetic Variation of Lasiodiplodia (Botryosphaeriaceae, Botryosphaeriales) Infecting Fruit Crops in Taiwan. J. Fungi 2023, 9, 950. [Google Scholar] [CrossRef] [PubMed]
- Alves, A.; Crous, P.W.; Correia, A.C.M.; Phillips, A.J.L. Morphological and molecular data reveal cryptic species in Lasiodiplodia theobromae. Fungal Divers. 2008, 28, 1–13. [Google Scholar]
- de Silva, N.I.; Phillips, A.J.L.; Liu, J.K.; Lumyong, S.; Hyde, K.D. Phylogeny and morphology of Lasiodiplodia species associated with Magnolia forest plants. Sci. Rep. 2019, 9, 14355. [Google Scholar] [CrossRef] [PubMed]
- Slippers, B.; Fourie, G.; Crous, P.W.; Coutinho, T.A.; Wingfield, B.D.; Wingfield, M.J. Multiple gene sequences delimit Botryosphaeria australis sp. nov. from B. lutea. Mycologia 2004, 96, 1030–1041. [Google Scholar] [CrossRef] [PubMed]
- Marques, M.W.; Lima, N.B.; de Morais, M.A., Jr.; Michereff, S.J.; Phillips, A.J.L.; Câmara, M.-P.S. Botryosphaeria, Neofusicoccum, Neoscytalidium and Pseudofusicoccum species associated with mango in Brazil. Fungal Divers. 2013, 61, 195–208. [Google Scholar] [CrossRef]
- Slippers, B.; Johnson, G.I.; Crous, P.W.; Coutinho, T.A.; Wingfield, B.D.; Wingfield, M.J. Phylogenetic and morphological re-evaluation of the Botryosphaeria species causing diseases of Mangifera indica. Mycologia 2005, 97, 99–110. [Google Scholar] [CrossRef]

| Location * | Production Method ** | Tree Density | Fertilisation *** | Cultivation **** | Pre-Culture | Surrounding Vegetation | Harvesting Method |
|---|---|---|---|---|---|---|---|
| R8 | O | 2 × 3 | NA | UC | Low shrubbery | Olive grove | Manual |
| IKB9 | C | 6 × 6 | CAN | C | Grains, vineyards, forage crops | Olive grove | Handheld shakers |
| IMK9 | C | 6 × 6 | CAN | C | Grains, vineyards, forage crops | Vineyards, forest | Handheld shakers |
| V12 | C | 5 × 5 | NA | UC | Forest, meadow | Olive grove | Tractor-mounted shakers |
| V16 | O | 6 × 6 and 8 × 8 | NA | C | Fruit trees | Olive grove, forest | Handheld shakers |
| N17 | C | 6 × 7 and 5 × 6 | CAN | UC | Low shrubbery, meadow | Vineyards, forest | Manual, handheld shakers |
| R18 | C | 6 × 6 | CAN | C | Vineyards | Meadow, field, forest | Handheld shakers |
| R19 | C | 6 × 6 | Stallatico | C | Vineyards | Olive grove, vineyards, meadow, forest | Manual, handheld shakers |
| PL1 | C | 10 | NA | UC | Low shrubbery, meadow | Olive trees located by the sea, surrounded by a forest | Manual |
| V21 | C/I | 6 × 6, 5 × 7 and 7 × 7 | Sheep manure, compost | C/UC | Olive | Olive grove | Handheld shakers |
| Species | Conidial Size (µm) | ||
|---|---|---|---|
| Length × Width * | Average ± SD ** | 95% Conf. *** | |
| Botryosphaeria dothidea | (20.0) 22.9–24.2 (27.3) ± (5.1) 6.0–6.6 (7.8) | 23.5 ± 1.9 × 6.3 ± 0.8 | 0.7–0.3 |
| Diplodia mutila | (20.4) 23.5–24.8 (27.4) ± (9.1) 10.8–11.6 (14.2) | 24.1 ± 1.8 ×11.2 ± 1.1 | 0.6–0.4 |
| Diplodia seriata | (16.2) 22.1–23.7 (27.6) ± (8.3) 10.7–11.7 (13.9) | 22.9 ± 2.1 × 11.2 ± 1.3 | 0.8–0.5 |
| Dothiorella iberica | (15.7) 20.4–21.7 (23.9) ± (7.1) 8.4–9.1 (10.7) | 21.0 ± 1.8 × 8.7 ± 0.9 | 0.7–0.4 |
| Dothiorella sarmentorum | (15.5) 18.9–20.1 (22.9) ± (7.3) 8.3–8.9 (10.9) | 19.5 ± 1.7 × 8.6 ± 0.9 | 0.6–0.3 |
| Neofusicoccum parvum | (9.2) 11.7–12.6 (15.5) ± (3.6) 5.4–6.0 (7.1) | 12.2 ± 1.3 × 5.7 ± 0.9 | 0.5–0.3 |
| Temperature (°C) | Botryosphaeria dothidea | Diplodia mutila | Diplodia seriata | Dothiorella iberica | Dothiorella sarmentorum | Neofusicoccum parvum |
|---|---|---|---|---|---|---|
| Growth of Mycelium (mm) | ||||||
| 5 | 0 | 0 | 0 | 0 | 0 | 0 |
| 10 | 2.58 | 5.16 | 8.5 | 11.0 | 18.33 | 7.03 |
| 15 | 8.87 | 12.0 | 19.16 | 23.5 | 38.0 | 10.21 |
| 20 | 24.29 | 33.3 | 45.33 | 45.66 | 57.0 | 28.16 |
| 25 | 39.04 | 48.33 | 55.0 | 50.33 | 57.41 | 40.95 |
| 30 | 30.17 | 31.16 | 44.66 | 7.16 | 16.83 | 51.95 |
| 35 | 16.47 | 1.83 | 4.16 | 0 | 0 | 5.04 |
| 40 | 0 | 0 | 0 | 0 | 0 | 0 |
| Species | Cardinal Temperatures (°C) for Mycelial Growth Based on Empirically Determined Growth Rate Values | Cardinal Temperatures (°C) for Mycelial Growth Estimated through Mathematical Modelling | ||||
|---|---|---|---|---|---|---|
| Minimum | Optimal | Maximum | Minimum | Optimal | Maximum | |
| Botryosphaeria dothidea | 5–10 | 25 | 35–40 | 5.1 | 25.7 | 39.9 |
| Diplodia mutila | 5–10 | 25 | 35–40 | 5.1 | 24.9 | 35.3 |
| Diplodia seriata | 5–10 | 25 | 35–40 | 5.1 | 25.4 | 35.6 |
| Dothiorella iberica | 5–10 | 25 | 30–35 | 5.1 | 26.9 | 31.8 |
| Dothiorella sarmentorum | 5–10 | 25 | 30–35 | 5.2 | 21.3 | 34.3 |
| Neofusicoccum parvum | 5–10 | 30 | 35–40 | 5.4 | 28.1 | 35.5 |
| Isolate | Species | GenBank Accession Number | ||
|---|---|---|---|---|
| ITS | TUB2 | TEF1-α | ||
| R8 NP | Botryosphaeria dothidea | OQ338370 | OQ348378 | OQ348385 |
| PL1 NP | Botryosphaeria dothidea | OQ352832 | OQ361692 | OQ553927 |
| N17 BJA3 | Botryosphaeria dothidea | OQ353073 | OQ361697 | OQ553926 |
| R19 F | Botryosphaeria dothidea | OQ354201 | OQ361700 | OQ361701 |
| IKB9 B2II | Diplodia mutila | OQ338569 | OQ348379 | OQ348386 |
| V16 K2II | Diplodia seriata | OQ352870 | OQ361695 | OQ361696 |
| V16 BI | Dothiorella iberica | OQ339205 | OQ348381 | OQ348388 |
| V12 PEN | Dothiorella sarmentorum | OQ339150 | OQ348380 | OQ348387 |
| R18 PEN1 | Dothiorella sarmentorum | OQ341230 | OQ348383 | OQ348390 |
| IMK9 IBVI | Neofusicoccum parvum | OQ352837 | OQ361693 | OQ361694 |
| V16 K1 | Neofusicoccum parvum | OQ341191 | OQ348382 | OQ348389 |
| R18 B1 | Neofusicoccum parvum | OQ353087 | OQ361698 | OQ361699 |
| V21 B5I | Neofusicoccum parvum | OQ341428 | OQ348384 | OQ553928 |
| Species | Variety * | |||
|---|---|---|---|---|
| Buža | Istarska Bjelica | Leccino | Rosinjola | |
| Botryosphaeria dothidea | 9.30 ± 3.69 b | 31.75 ± 11.88 c | 65.41 ± 17.82 a | 12.87 ± 6.26 b |
| Diplodia mutila | 19.16 ± 6.27 a | 84.33 ± 33.28 b | 44.95 ± 20.75 b | 22.25 ± 6.36 a |
| Diplodia seriata | 5.50 ± 1.85 b | 11.15 ± 5.25 c | 5.10 ± 2.32 c | 10.05 ± 5.41 bc |
| Dothiorella iberica | 5.50 ± 1.03 b | 3.65 ± 1.93 c | 3.75 ± 2.02 c | 4.95 ± 2.85 cd |
| Dothiorella sarmentorum | 4.70 ± 1.92 bc | 4.55 ± 1.42 c | 53.99 ± 20.04 ab | 4.85 ± 0.75 cd |
| Neofusicoccum parvum | 16.15 ± 5.32 a | 320.75 ± 87.39 a | 48.45 ± 18.69 ab | 24.11 ± 7.87 a |
| Control | 0.0 ± 0.0 c | 0.0 ± 0.0 c | 0.0 ± 0.0 c | 0.0 ± 0.0 d |
| Minimum significant difference | 4.87 | 48.62 | 19.99 | 6.90 |
| Isolate | Location | Coordinates | Variety from Which Sample Was Taken | Collection Date | Olive Grove Area (Ha) | Tree Age (Years) |
|---|---|---|---|---|---|---|
| R8 NP | Rovinj | 45°05′20″ N, 13°38′51″ E | Unknown | 6 September 2021 | 0.01 | 15 |
| IKB9 B2II | Poreč | 45°13′19.9″ N, 13°36′07.7″ E | Buža | 13 September 2021 | 1.49 | >30 |
| IMK9 IBVI | Poreč | 45°13′13″ N 13°36′09.8″ E | Istarska bjelica | 13 September 2021 | 1.49 | >30 |
| V12 PEN | Vodnjan | 44°57′65″ N, 13°50′19″ E | Pendolino | 24 September 2021 | 0.1 | 20–100 |
| V16 BI | Fažana near Vodnjan | 44°56′21″ N; 13°50′18″ E | Buža | 14 October 2021 | 1 | 13 |
| V16 K1 | Karbonaca | |||||
| V16 K2II | Karbonaca | |||||
| N17 BJA3 | Novigrad | 45°20′08.8″ N, 13°33′33.6″ E | Istarska bjelica | 14 October 2021 | 3 | 20–25 |
| R18 B1 | Rovinj | 45°03′02.2″ N 13°42′43.9″ E | Buža | 14 October 2021 | 0.43 | 39 |
| R18 PEN1 | Pendolino | |||||
| R19 F | Rovinj | 45°03′46″ N, 13°42′71″ E | Frantoio | 14 October 2021 | 0.38 | 25–30 |
| PL1 NP | Poreč | 45°12′26″ N 13°35′29″ E | Unknown | 23 March 2022 | 0.02 | 10 |
| V21 B5I | Vodnjan | 44°57′34″ N, 13°50′37″ E | Buža | 24 March 2022 | 8.2 | 12–300 |
| Species | Isolate | Host | Country | GenBank Accession Number | References | ||
|---|---|---|---|---|---|---|---|
| ITS | TUB2 | TEF1-α | |||||
| Biscogniauxia mediterranea | Bm04.001 | Quercus suber L. | Portugal | KM216752 | KM267202 | KM216788 | [68] |
| B. mediterranea | Bm10.019 | Q. suber | Portugal | KM216761 | KM267210 | KM216797 | [68] |
| Botryosphaeria corticis (Demaree & Wilcox) Arx & E. Mull. | ATCC 22927 | Vaccinium corymbosum L. | USA | DQ299247 | EU673108 | EU673291 | [33,69] |
| Bo. corticis | CBS119047 | V. corymbosum | USA | DQ299245 | EU673107 | EU017539 | [33,69] |
| Bo. corticis | CBS119048 | V. corymbosum | USA | DQ299246 | MT592464 | EU017540 | [33,69] |
| Bo. dothidea (Moug. ex Fr.) Ces. & De Not. | CBS110302 | Vitis vinifera L. | Portugal | AY259092 | EU673106 | AY573218 | [70,71,72] |
| Bo. dothidea | CMW8000 | Prunus sp. | Switzerland | AY236949 | AY236927 | AY236898 | [63] |
| Bo. dothidea | BJS-01s | V. vinifera | China | JX275778 | JX462259 | JX462285 | [49] |
| Bo. pseudoramosa G.Q. Li & S.F. Chen | CERC 2001 | Eucalyptus urophylla × Eucalyptus grandis | China | KX277989 | KX278198 | KX278094 | [73] |
| Bo. pseudoramosa | CERC 3455 | E. urophylla × E. grandis | China | KX277997 | KX278206 | KX278102 | [73] |
| Bo. pseudoramosa | CERC 3472 | E. urophylla × E. grandis | China | KX277999 | KX278208 | KX278104 | [73] |
| Bo. qingyuanensis G.Q. Li & S.F. Chen | CERC 2947 | E. urophylla × E. grandis | China | KX278001 | KX278210 | KX278106 | [73] |
| Bo. qingyuanensis | CERC 2946 | E. urophylla × E. grandis | China | KX278000 | KX278209 | KX278105 | [73] |
| Bo. qingyuanensis | TKBQ16-30 | Carya cathayensis Sarg. | China | MW561677 | MW561777 | MW561687 | [74] |
| Diplodia bulgarica A.J.L. Phillips, J. Lopes & S.G. Bobev | UCD11351 | Malus domestica (Suckow) Borkh. | USA | OR631210 | OR637362 | OR637364 | [75] |
| D. bulgarica | UCD11350 | M. domestica | USA | OR631209 | OR637361 | OR637363 | [75] |
| D. bulgarica | CBS124136 | M. sylvestris (L.) Mill. | Bulgaria | MH863355 | MT592475 | GQ923822 | [76,77,78] |
| D. corticola A.J.L. Phillips, A. Alves & J. Luque | CBS 112546 | Q. ilex L. | Spain | AY259090 | EU673117 | EU673310 | [70,72] |
| D. corticola | CBS 112549 | Q. suber | Portugal | AY259100 | DQ458853 | AY573227 | [70,71] |
| D. corticola | UCD1260So | V. vinifera | California | GU799470 | GU799464 | GU799467 | [79] |
| D. cupressi A.J.L. Phillips & A. Alves | CBS168.87 | Cupressus sempervirens L. | Israel | DQ458893 | DQ458861 | DQ458878 | [80] |
| D. cupressi | CBS261.85 | C. sempervirens | Israel | DQ458894 | DQ458862 | DQ458879 | [80] |
| D. cupressi | CBS121027 | C. sempervirens | Cyprus | MT587340 | MT592487 | MT592045 | [78] |
| D. mutila | CBS112553 | V. vinifera | Portugal | AY259093 | MZ073931 | AY573219 | [70,71,81] |
| D. mutila | CBS230.30 | Phoenix dactylifera L. | USA | DQ458886 | DQ458849 | DQ458869 | [80] |
| D. mutila | PD75 | Holly | USA | GU251119 | GU251779 | GU251251 | [82] |
| D. seriata De Notaris | UCD244Ma | V. vinifera | California | DQ008314 | DQ008337 | EU012406 | [79] |
| D. seriata | CBS 112555 | V. vinifera | Portugal | AY259094 | DQ458856 | AY573220 | [70] |
| D. seriata | SDZ-01 | V. vinifera | China | HQ629954 | HQ629956 | HQ629958 | [49] |
| Dothiorella brevicollis Jami, Gryzenh., Slippers & M.J. Wingf. | CMW36463 | Vachellia karroo (Hayne) Banfi & Galasso | South Africa | JQ239403 | JQ239371 | JQ239390 | [83] |
| Do. brevicollis | CMW36464 | V. karroo | South Africa | JQ239404 | JQ239372 | JQ239391 | [83] |
| Do. brevicollis | CBS130412 | V. karroo | South Africa | MT587395 | MT592578 | MT592107 | [78] |
| Do. dulcispinae Jami, Gryzenh., Slippers & M.J. Wingf. | CMW36460 | V. karroo | South Africa | JQ239400 | JQ239373 | JQ239387 | [83] |
| Do. dulcispinae | CMW36461 | V. karroo | South Africa | JQ239401 | JQ239374 | JQ239388 | [83] |
| Do. dulcispinae | CMW36462 | V. karroo | South Africa | JQ239402 | JQ239375 | JQ239389 | [83] |
| Do. iberica A.J.L. Phillips, J. Luque & A. Alves | CBS115041 | Q. ilex | Spain | NR111165 | EU673096 | AY573222 | [72,84] |
| Do. iberica | UCRDI3 | Prunus dulcis (Mill.) D.A.Webb | California | KP012591 | KP067201 | KP828802 | [85] |
| Do. iberica | UCRDI1 | P. dulcis | California | KP012590 | KP067200 | KP828801 | [85] |
| Do. oblonga F.J.J. van der Walt, Slippers & G.J. Marais | CBS130414 | V. karroo | South Africa | MT587408 | MT592598 | MT592120 | [78] |
| Do. oblonga | CBS121766 | Senegalia mellifera (Vahl) L.A. Silva & J. Freitas | South Africa | EU101301 | KX464863 | EU101346 | [86,87] |
| Do. oblonga | CBS121765 | S. mellifera | South Africa | KF766163 | KX464862 | EU101345 | [86,87,88] |
| Do. sarmentorum (Fr.) A.J.L. Phillips, Alves & Luque | CMW39366 | Aesculus hippocastanum L. | Serbia | KF575009 | KF575105 | KF575047 | [89] |
| Do. sarmentorum | PD78 | P. dulcis | California | GU251169 | GU251829 | GU251301 | [82] |
| Do. sarmentorum | CBS115038 | Malus pumila Mill. | Netherlands | AY573206 | EU673101 | AY573223 | [71] |
| Lasiodiplodia crassispora T.I. Burgess & P.A. Barber | UCD27Co | V. vinifera | California | GU799457 | GU799480 | GU799488 | [90] |
| L. crassispora | CMW13488 | Eucalyptus urophylla S.T. Blake | Venezuela | DQ103552 | KU887507 | DQ103559 | [91,92] |
| L. crassispora | UCD24Co | V. vinifera | California | GU799456 | GU799479 | GU799487 | [90] |
| L. gonubiensis Pavlic, Slippers & M.J. Wingf | CBS115812 | Syzygium cordatum Hochst. | South Africa | DQ458892 | DQ458860 | DQ458877 | [80] |
| L. gonubiensis | CMW36240 | Adansonia sp. | Africa | KU887124 | KU887502 | KU887001 | [92] |
| L. gonubiensis | CMW43763 | Bruguiera gymnorhiza (L.) Savigny | South Africa | KU587955 | KU587865 | KU587944 | [93] |
| L. iranensis Abdollahz., Zare & A.J.L. Phillips | PCoCo10 | Theobroma cacao L. | Taiwan | OR534188 | OR551954 | OR552312 | [94] |
| L. iranensis | PCoCo11 | T. cacao | Taiwan | OR534189 | OR551955 | OR552313 | [94] |
| L. iranensis | PCoCo12 | T. cacao | Taiwan | OR534190 | OR551956 | OR552314 | [94] |
| L. pseudotheobromae A.J.L. Phillips, A. Alves & Crous | CBS116459 | Gmelina arborea Roxb. ex Sm. | Costa Rica | EF622077 | EU673111 | EF622057 | [72,95] |
| L. pseudotheobromae | MFLUCC 18-1120 | Magnolia liliifera (L.) L. | China | MK496933 | MK524719 | MK521585 | [96] |
| L. pseudotheobromae | MFLUCC 18-0950 | M. liliifera | China | MK501818 | MK550605 | MK521586 | [96] |
| L. theobromae (Pat.) Griffon & Maubl. | CAA006 | V. vinifera | USA | DQ458891 | DQ458859 | DQ458876 | [80] |
| L. theobromae | GX-5-5A | V. vinifera | China | JX275780 | JX462262 | JX462288 | [49] |
| L. theobromae | TJXHS1S1 | V. vinifera | China | JX275790 | JX462278 | JX462304 | [49] |
| N. arbuti (D.F. Farr & M. Elliott) Crous, Slippers & A.J.L. Phillips | CBS116576 | Arbutus menziesii Pursh | USA | KX464156 | KX464928 | KX464651 | [87] |
| N. arbuti | CBS116574 | A. menziesii | USA | KX464154 | KX464926 | KX464649 | [87] |
| N. arbuti | CBS116573 | A. menziesii | USA | KX464153 | KX464925 | KX464648 | [87] |
| N. australe | CMW6837 | Acacia sp. | Australia | AY339262 | AY339254 | AY339270 | [97] |
| N. australe | CMW9073 | Acacia sp. | Australia | AY339261 | AY339253 | AY339269 | [97] |
| N. australe | CMW6853 | Sequoiadendron giganteum (Lindl.) J. Buchholz | Australia | AY339263 | AY339255 | AY339271 | [97] |
| N. brasiliense M.W. Marques, A.J.L. Phillips & M.P.S. Camara | CMM1285 | Mangifera indica L. | Brazil | JX513628 | KC794030 | JX513608 | [98] |
| N. brasiliense | CMM1338 | M. indica | Brazil | JX513630 | KC794031 | JX513610 | [98] |
| N. brasiliense | CMM1269 | M. indica | Brazil | JX513629 | KC794032 | JX513609 | [98] |
| N. hongkongense G.Q. Li & S.F. Chen | CERC 2967 | Araucaria cunninghamii Mudie | China | KX278050 | KX278259 | KX278155 | [73] |
| N. hongkongense | CERC 2968 | A. cunninghamii | China | KX278051 | KX278260 | KX278156 | [73] |
| N. hongkongense | CERC 2973 | A. cunninghamii | China | KX278052 | KX278261 | KX278157 | [73] |
| N. mangroviorum J.A. Osorio, Jol. Roux & Z.W. de Beer | CPC32482 | Diospyros dichrophylla (Gand.) De Winter | South Africa | MT587494 | MT592701 | MT592209 | [78] |
| N. mangroviorum | CMW41365 | Avicennia marina (Forssk.) Vierh. | South Africa | KP860859 | KP860779 | KP860702 | [93] |
| N. mangroviorum | CMW42481 | Bruguiera gymnorhiza (L.) Savigny, | South Africa | KP860848 | KP860770 | KP860692 | [93] |
| N. mangiferae (Syd. & P.Syd.) Crous et al. | CMW7024 | Magnifera indica L. | Australia | AY615185 | AY615172 | DQ093221 | [99] |
| N. mangiferae | CMW7797 | M. indica | Australia | AY615186 | AY615173 | DQ093220 | [99] |
| N. mangiferae | CMW7081 | M. indica | Australia | AY615187 | AY615174 | KF766425 | [99] |
| N. microconidium | CERC 3497 | E. urophylla × E. grandis | China | KX278053 | KX278262 | KX278158 | [73] |
| N. microconidium | CERC 3498 | E. urophylla × E. grandis | China | KX278054 | KX278263 | KX278159 | [73] |
| N. microconidium | CBS118821 | Syzygium cordatum Hochst. | South Africa | MT587497 | MT592704 | MT592212 | [78] |
| N. luteum (Pennycook & Samuels) Crous, Slippers & A.J.L. Phillips | CBS110299 | V. vinifera | Portugal | AY259091 | DQ458848 | AY573217 | [70,71] |
| N. luteum | CBS110497 | V. vinifera | Portugal | EU673311 | EU673092 | EU673277 | [72] |
| N. luteum | CBS133502 | Persea americana Mill. | USA | MT587483 | MT592689 | MT592197 | [78] |
| N. parvum (Pennycook & Samuels) Crous, Slippers & A.J.L. Phillips | CBS110301 | V. vinifera | Portugal | AY259098 | EU673095 | AY573221 | [70,71,72] |
| N. parvum | CMW9081 | Populus nigra L. | New Zealand | AY236943 | AY236917 | AY236888 | [97] |
| N. parvum | CBS123652 | S. cordatum | South Africa | KX464184 | KX464996 | KX464710 | [87] |
| N. parvum | Zai-5 | Syzygium samarangense Merr. & L.M. Perry | Taiwan | OR534045 | OR551811 | OR552360 | [94] |
Disclaimer/Publisher’s Note: The statements, opinions and data contained in all publications are solely those of the individual author(s) and contributor(s) and not of MDPI and/or the editor(s). MDPI and/or the editor(s) disclaim responsibility for any injury to people or property resulting from any ideas, methods, instructions or products referred to in the content. |
© 2024 by the authors. Licensee MDPI, Basel, Switzerland. This article is an open access article distributed under the terms and conditions of the Creative Commons Attribution (CC BY) license (https://creativecommons.org/licenses/by/4.0/).
Share and Cite
Petrović, E.; Vrandečić, K.; Belušić Vozila, A.; Ćosić, J.; Godena, S. Diversity and Pathogenicity of Botryosphaeriaceae Species Isolated from Olives in Istria, Croatia, and Evaluation of Varietal Resistance. Plants 2024, 13, 1813. https://doi.org/10.3390/plants13131813
Petrović E, Vrandečić K, Belušić Vozila A, Ćosić J, Godena S. Diversity and Pathogenicity of Botryosphaeriaceae Species Isolated from Olives in Istria, Croatia, and Evaluation of Varietal Resistance. Plants. 2024; 13(13):1813. https://doi.org/10.3390/plants13131813
Chicago/Turabian StylePetrović, Elena, Karolina Vrandečić, Andreina Belušić Vozila, Jasenka Ćosić, and Sara Godena. 2024. "Diversity and Pathogenicity of Botryosphaeriaceae Species Isolated from Olives in Istria, Croatia, and Evaluation of Varietal Resistance" Plants 13, no. 13: 1813. https://doi.org/10.3390/plants13131813
APA StylePetrović, E., Vrandečić, K., Belušić Vozila, A., Ćosić, J., & Godena, S. (2024). Diversity and Pathogenicity of Botryosphaeriaceae Species Isolated from Olives in Istria, Croatia, and Evaluation of Varietal Resistance. Plants, 13(13), 1813. https://doi.org/10.3390/plants13131813








